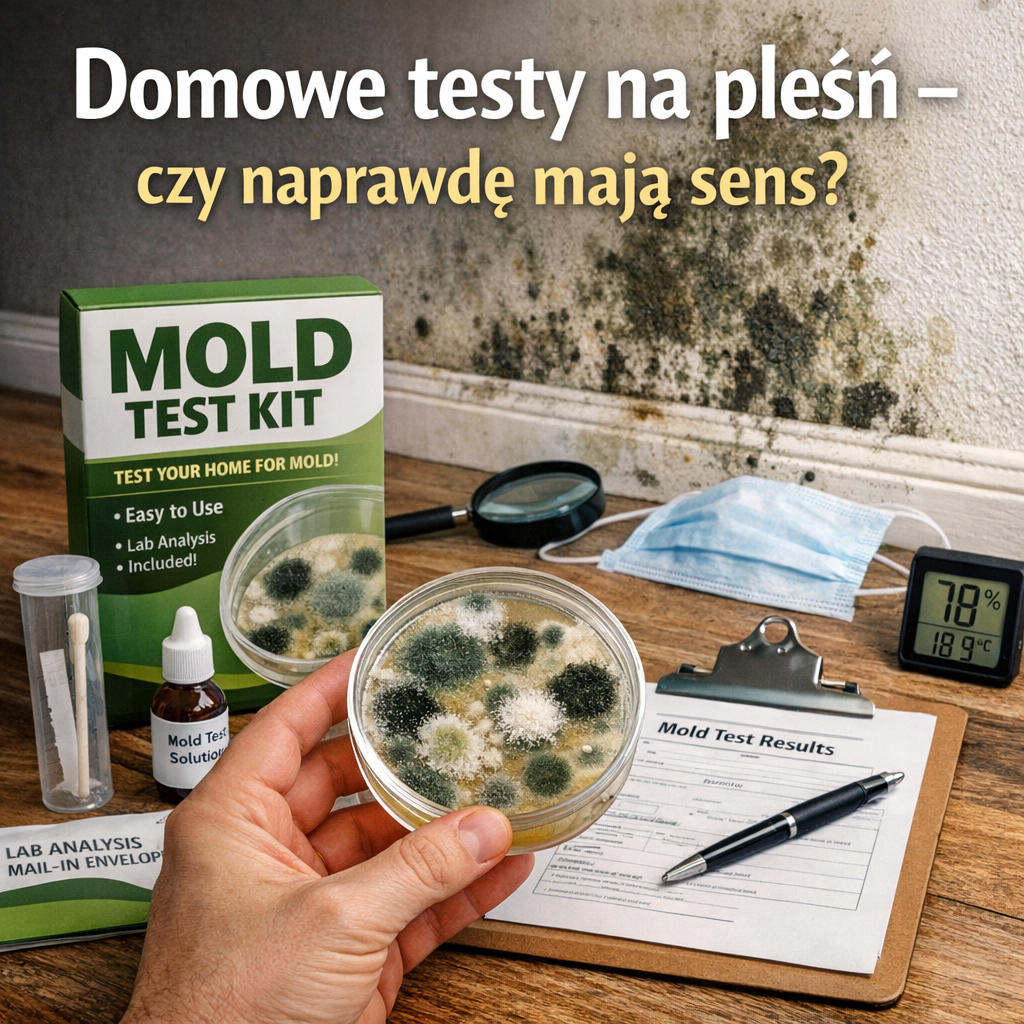
Domowe testy na pleśń – czy naprawdę mają sens?

Domowe testy na pleśń – czy naprawdę mają sens?
Wiele osób widzi ciemną plamkę przy oknie albo czuje stęchły zapach i od razu myśli: pleśń. Wtedy często pojawia się pytanie: Domowe testy na pleśń – czy naprawdę mają sens? Z mojej praktyki kontaktu z mieszkaniami po zalaniach i zagrzybionymi łazienkami wynika, że sens mogą mieć, ale tylko wtedy, gdy rozumiemy ich ograniczenia.
Domowe testy bywają jak latarka we mgle. Pomagają coś dostrzec, ale nie pokażą całego obrazu. Pleśń to nie tylko „czarne kropki” na ścianie. To też zarodniki w powietrzu, wilgoć w przegrodach i problem z wentylacją. Dlatego warto podejść do tematu spokojnie i krok po kroku.
Domowe testy na pleśń – czy naprawdę mają sens?
Jeśli rozumiemy, co test mierzy, a czego nie mierzy, może być pomocny. Najczęściej w domach spotyka się proste testy płytkowe (osadzanie z powietrza) albo „wymazy” z powierzchni.
Problem w tym, że wynik nie zawsze mówi, czy w domu dzieje się realnie coś groźnego. Pleśń występuje w środowisku naturalnie. Zarodniki są w powietrzu prawie wszędzie, więc sam fakt, że „coś wyrosło”, nie musi oznaczać awarii w mieszkaniu.
Co tak naprawdę pokazują domowe testy na pleśń – czy naprawdę mają sens?
Test płytkowy najczęściej pokazuje, że w powietrzu były zarodniki, które spadły na pożywkę i zaczęły rosnąć. I tyle. Nie mówi:
- czy stężenie zarodników jest wysokie w porównaniu do tła na zewnątrz
- czy źródło jest w mieszkaniu, czy np. przyszło z klatki schodowej
- jakie to gatunki (a to bywa ważne przy alergiach)
- czy pleśń rośnie „w ścianie”, a nie na powierzchni
Wymaz z plamy na ścianie może potwierdzić, że to faktycznie kolonia grzybów, a nie brud. Ale nadal nie odpowie na kluczowe pytanie: dlaczego to rośnie i jak daleko problem zaszedł.
Jeśli chcesz porównać podejścia do usuwania skutków wilgoci w domu, czasem przydają się też rozwiązania związane z bezpiecznym czyszczeniem powierzchni, ale najpierw warto ustalić źródło problemu, żeby nie wracał.
Domowe testy na pleśń – czy naprawdę mają sens?
Największy błąd, jaki widuję, to traktowanie testu domowego jako „wyroku”. Jeśli wyszło coś na płytce, ktoś wpada w panikę. Jeśli nie wyszło nic, ktoś uznaje, że temat nie istnieje. A pleśń potrafi rosnąć w miejscach, których test nie obejmie, np. za listwą, w warstwie ocieplenia albo pod panelami.
Domowe testy łatwo też zepsuć przez warunki wykonania. Otwierasz okno, robisz test w przeciągu, gotujesz obiad, sprzątasz, wietrzysz. Każde takie działanie zmienia to, co „wpadnie” na pożywkę. W efekcie wynik może być bardziej losowy, niż się wydaje.
Najczęstsze pułapki i błędne interpretacje
- Test w jednym miejscu: a problem jest w innym pokoju albo za szafą
- Brak porównania z zewnątrz: bez tego trudno powiedzieć, czy w środku jest „więcej niż normalnie”
- Brak pomiaru wilgotności i wentylacji: a to zwykle sedno sprawy
- Zbyt szybkie czyszczenie plam bez osuszenia: nawrót jest niemal pewny
W praktyce lepiej myśleć o teście jako o sygnale pomocniczym. Takim, który mówi: „sprawdźmy to dokładniej”, a nie: „już wszystko wiem”.
Jeśli po drodze szukasz spokojnie opisanych informacji o pracy z trudnymi zabrudzeniami i skutkami zawilgoceń, pamiętaj, że czyszczenie to tylko połowa sukcesu. Druga połowa to usunięcie przyczyny wilgoci.
Domowe testy na pleśń – czy naprawdę mają sens?
Tak, ale pod pewnymi warunkami. Domowe testy mają najwięcej sensu wtedy, gdy łączysz je z obserwacją domu i prostymi pomiarami. Pleśń lubi wilgoć, a wilgoć lubi brak przewiewu. Dlatego warto sprawdzić podstawy.
Co możesz zrobić zamiast polegać tylko na teście
Oto prosty zestaw działań, które zwykle dają więcej niż sama płytka:
- Zmierz wilgotność w mieszkaniu higrometrem (szczególnie rano i po kąpieli)
- Sprawdź, czy działa wentylacja (kratka w łazience i kuchni)
- Obejrzyj narożniki zewnętrznych ścian, okolice okien, miejsca za meblami
- Zwróć uwagę na zapach stęchlizny po dłuższym zamknięciu mieszkania
- Poszukaj śladów po zalaniu lub przeciekach, nawet starych
Jeśli masz w domu osoby z astmą, silną alergią albo małe dzieci, warto potraktować temat poważniej. W takich sytuacjach często lepszym krokiem jest konsultacja z fachowcem, który oceni wilgotność przegród i wskaże źródło problemu, zamiast opierać decyzje tylko na wyniku domowego testu.
Bywa też, że po usunięciu wilgoci zostają plamy, naloty lub resztki starych powłok. Wtedy znaczenie ma dobór metody czyszczenia i bezpieczeństwo materiałów. Czasem przydatne są technologie do pracy z trudnymi powierzchniami, ale kluczowe jest, by nie maskować problemu farbą bez osuszenia i poprawy wentylacji.
Domowe testy na pleśń – czy naprawdę mają sens?
Jeśli chcesz odpowiedzieć sobie uczciwie na pytanie: Domowe testy na pleśń – czy naprawdę mają sens?, potraktuj je jako narzędzie wstępne, a nie dowód ostateczny. Test może potwierdzić Twoje podejrzenia albo zmotywować do działania. Nie powinien jednak zastępować oceny źródła wilgoci.
Kiedy test domowy wystarczy, a kiedy nie
Test domowy może wystarczyć, gdy:
- widzisz małą plamę na powierzchni i chcesz sprawdzić, czy to pleśń
- pojedynczy problem pojawił się po jednorazowym zdarzeniu (np. słabe dosuszenie po remoncie)
- masz stabilną wilgotność w mieszkaniu i działającą wentylację, a chcesz tylko potwierdzenia
Lepiej pominąć test i przejść do dokładniejszej diagnozy, gdy:
- pleśń wraca mimo sprzątania
- czujesz silny zapach stęchlizny, ale nie widać plam
- było zalanie, przeciek z dachu lub problem z instalacją
- domownicy mają nasilone objawy oddechowe
W takich przypadkach liczy się ustalenie przyczyny: skąd bierze się wilgoć, gdzie się gromadzi i czy budynek ma prawidłową wymianę powietrza. Bez tego każdy środek i każde czyszczenie będą tylko „ścieraniem dymu”, a nie gaszeniem ognia.
Na koniec: domowe testy mogą być dobrym startem, ale nie powinny uspokajać na siłę ani straszyć bez powodu. Jeśli chcesz działać rozsądnie, połącz obserwację, pomiar wilgotności i zdrowy dystans do wyniku testu. A gdy trzeba usunąć skutki i przywrócić powierzchnie do porządku, czasem przydają się sprawdzone metody czyszczenia, dobrane do materiału, oraz szczegóły pracy na porowatych podłożach, a przy trudnych powłokach także preparaty do usuwania starych warstw i warianty bezpiecznego postępowania. Jeśli temat dotyczy na przykład usuwania zaschniętych powłok z różnych powierzchni, pomocny bywa też dobór środka dopasowany do rodzaju podłoża.
Najważniejsze jest jedno: pleśń to sygnał, że w domu pojawiła się wilgoć. Test może ją zasugerować, ale to przyczyna wilgoci decyduje o tym, czy problem zniknie na dobre.